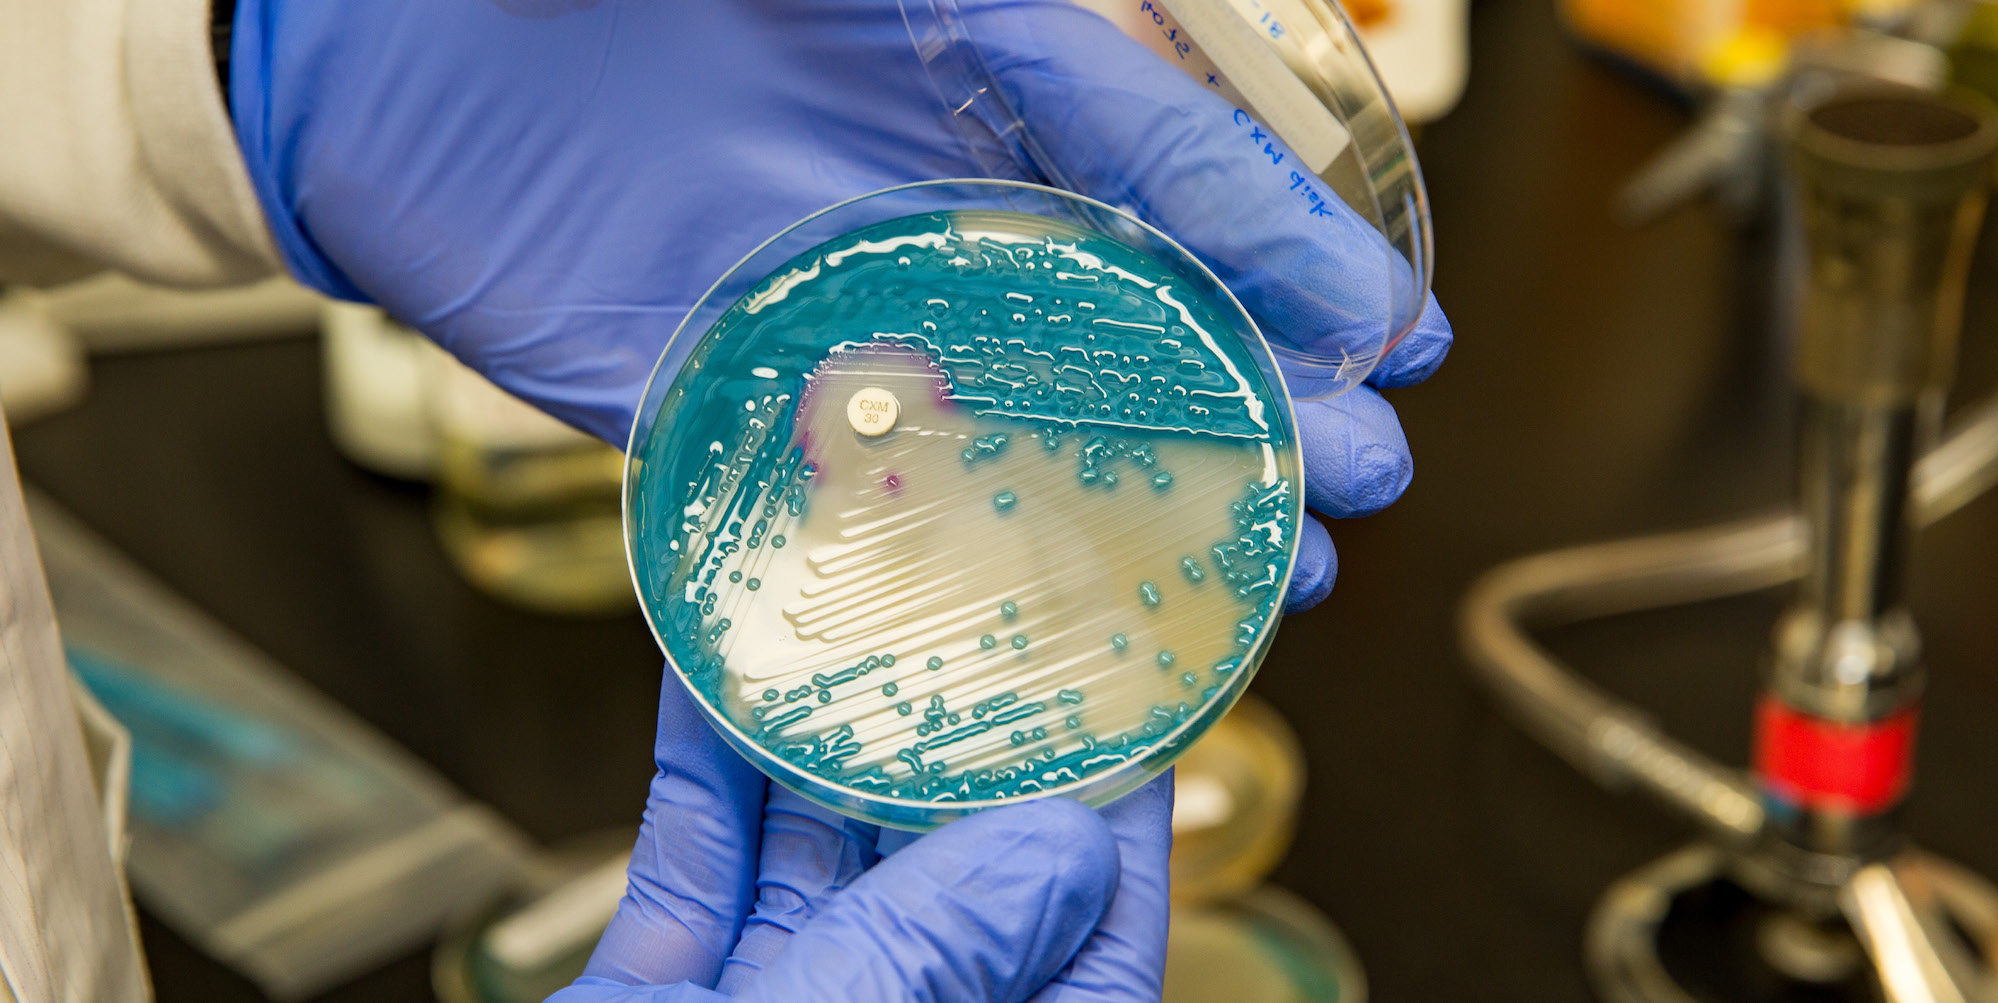
1 professor in his lab

Prospective Students
Our goal at UCI is to help our students learn their craft as scientists and at the same time become great leaders that go on to fulfilling and successful careers.
APPLICATION OPEN
October, 2025
APPLICATION DEADLINE
December 1, 2025
Why CMB?
Biomedical scientists in the 21st century must have a broad knowledge base and the skill to translate this knowledge towards disease treatment. The PhD program in Cellular & Molecular Biosciences at UC Irvine provides ideal training to launch the careers of talented researchers in diverse fields of biomedicine. With a multi-cultural student cohort, we strive to fulfill the dreams of students from many different backgrounds. The training environment is rigorous, but also cognizant of the need in life for a supportive and balanced lifestyle.
Our guaranteed on-campus housing contributes to a productive graduate experience. Visit the housing website for more information.
Qualified applicants receive full financial support that covers tuition, a generous stipend, and health insurance.
Outstanding research centers, facilities, and equipment assist our faculty and students in advancing the understanding of health and disease.
A collaborative culture that’s committed to diversity. UCI has been voted #1 “School doing most for the American Dream” by the New York Times.
Research
Researchers at UCI utilize state-of-the-art approaches in their pursuit of ground breaking discoveries.
Faculty

CMB faculty have chosen primary and secondary affiliations within five recently established Areas of Focus.
Fellowships

Highly qualified applicants are considered for prestigious awards that supplement the stipend in the first year of study.
Academics
We offer a rigorous but flexible curriculum, along with an extensive choice of laboratories, allowing students to tailor their training to individual interests and goals.
All Departments
CMB is an interdisciplinary program with six participating departments from two Schools, the UCI School of Medicine and UCI School of Biological Sciences.
Leading the way in the Biomedical Sciences
We invite you to learn more about the impact of our research, our faculty achievements, and how we are training the next generation of Biologists.
